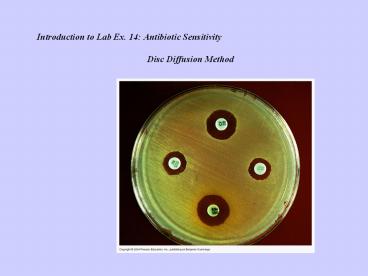

Antibiotic Sensitivity PowerPoint PPT Presentation
Title: Antibiotic Sensitivity
1
Introduction to Lab Ex. 14 Antibiotic
Sensitivity Disc Diffusion Method
2
Introduction to Lab 10 Ex. Antibiotic
Sensitivity Antibiotics are chemicals that are
produced by other bacteria/fungi that have the
ability to prevent other organisms (bacteria)
from growing or killing them. These have been
used widely in controlling bacterial infections
in humans that cause diseases in humans.
There have been many antibiotics that have been
developed. These have been found to be
effective in controlling various infectious
bacteria in humans and thus used extensively in
disease control (treatment of bacterial
infections)
3
While there are many different kinds of
antibiotics and still many more kinds of
bacteria, not all antibiotics are effective in
inhibiting all bacteria. Hence, it is essential
to determine whether an organism is sensitive
to the inhibitory action of the antibiotic or
not. Many procedures have been developed to
determine antibiotic sensitivity. The most
common method is the Disc diffusion method
Filter paper discs are saturated with specific
amounts of certain antibiotics and placed on a
growth of the particular bacterial culture to
be tested. If growth is inhibited then
sensitivity is seen If growth is seen then the
culture is resistant to the antibiotic action
and is not inhibited (which will mean that it
cannot be used to treat an infection by the
bacterium)
4
It has also been discovered that antibiotics
inhibit bacteria by stopping their growth
(bacteriostatic) or by killing them
(bactericidal). Antibiotics have been found to
have different modes of action to inhibit
bacteriadestruction of cell wall
destruction of cell membrane
inhibition of protein synthesis
inhibition of DNA synthesis inhibition
of intermediary metabolism Also, most
antibiotics are effective only against bacteria
(which have a prokaryotic cell structure and
processes different from eukaryotic cells
resulting in antibiotics being effective
primarily against prokaryotic cells i.e. other
bacteria)
5
The disc diffusion method - E.coli
representing the Gram negative organisms -
S.aureus representing the Gram positive
bacteria Antibiotics that are effective against
a wide range of bacteria (G and G-) are called
broad spectrum Those that have effect against a
small specific group of bacteria (either G or
G-) are called narrow spectrum.